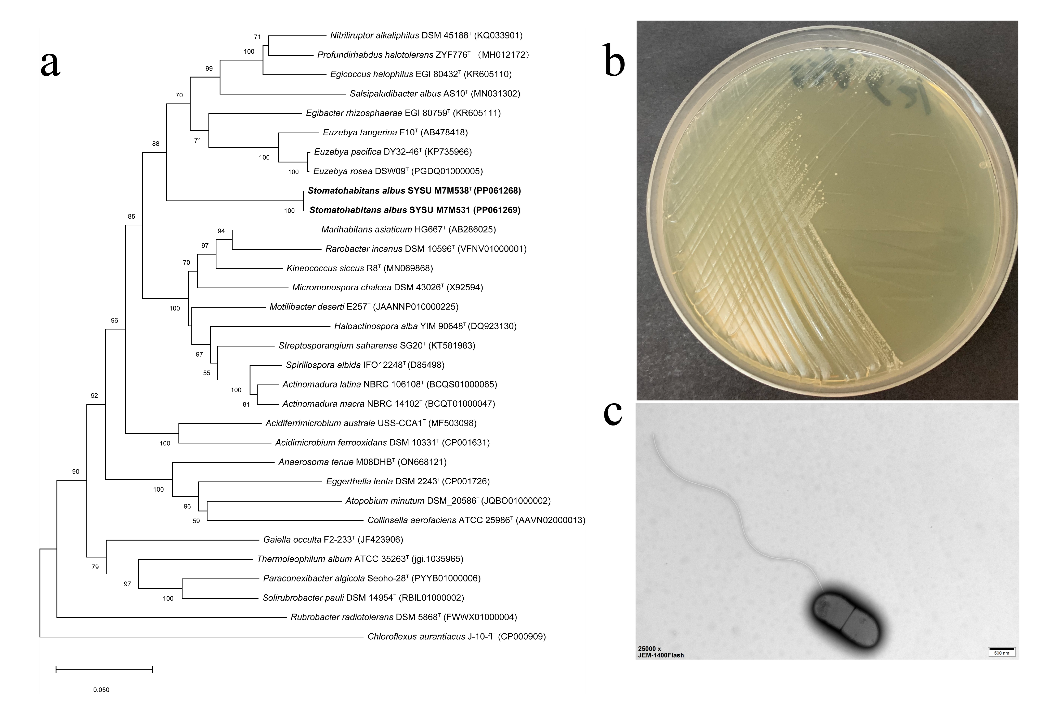

白菜官网李文均教授团队在海洋哺乳动物北海狮消化道微生物多样性研究方面取得积极进展
微生物在维持海洋哺乳动物的正常功能和健康方面发挥着至关重要的作用。获取微生物纯培养菌株不仅有助于明确微生物,如生长、代谢和生理生化功能等特征,还有助于微生物资源的开发和应用。北海狮是《国家重点保护野生动物名录》的二级保护动物,并被纳入《世界自然保护联盟》濒危物种红色名录。因此锁定和分离到北海狮宿主体内与其健康相关的肠道微生物,是深入探究微生物与动物健康关系的关建,也是诊断和治疗珍稀哺乳动物包括疾病在内的不良状态,提高珍稀哺乳动物保育水平的一个有效出口。

长隆海洋王国北海狮及其分布范围(长隆供图)
近期,白菜官网李文均教授团队联合广东长隆集团以及河南师范大学水产学院聂国兴教授在对北海狮的微生物多样性研究中取得了积极进展。课题组在针对广东长隆集团中饲养的鳍足类动物的粪便、口腔和皮肤样品进行了多次的微生物分离培养、鉴定和保藏工作,共分离获得了来自鳍足类动物肠道的1000余株细菌,通过对其中的623株菌进行16S rRNA基因的测序,发现有72株细菌可能是潜在新物种。其中,在北海狮口腔中分离获得了2株细菌(SYSU M7M538T和SYSU M7M531),通过多相分类的研究方法确定了这两株细菌代表着放线菌门里的一个新目级别的高级分类单元,并命名为白色口腔栖息菌(Stomatohabitans albus SYSU M7M538T)。
白色口腔栖息菌的系统发育关系及形态特征(a. 白色口腔栖息菌系统发育树;b. 白色口腔栖息菌菌落形态;c. 白色口腔栖息菌细胞透射电镜图)
大数据分析表明,该研究中发现的白色口腔栖息菌主要栖息于哺乳动物的口腔或其他消化道器官中,属于极稀有类群(最高丰度不超过0.3%)。不仅如此,基因组分析表明白色口腔栖息菌具有一个相比于其他放线菌缩小了接近一半的基因组(2.1-2.3 Mbp),以及与其他放线菌相比显著降低的基因组G+C含量(52.5-52.7%)。如此大规模的基因丢失表明白色口腔栖息菌与动物宿主之间存在密切的共生关系。代谢通路的注释结果发现白色口腔栖息菌缺乏许多重要代谢途径上的基因。如缺乏所有参与磷酸戊糖途径氧化阶段的基因,以及编码糖异生第一步的磷酸烯醇式丙酮酸羧激酶的基因。这些关键基因的缺失表明了白色口腔栖息菌在体外培养的困难,也进而证明了我们培养技术的独特和高超。有意思的是,白色口腔栖息菌又具有着其他腈基降解菌不具有的完整的硫胺素、生物素和血红素生物合成途径,这表明,白色口腔栖息菌在动物体内发挥重要作用,它们可能从动物宿主中获取营养,但是会产生维生素,从而促进宿主的生长。
该研究成果以“Stomatohabitans albus gen. nov., sp. nov., an oral living facultative anaerobic actinobacteria isolated form Steller sea lion, and proposal of Stomatohabitantaceae fam. nov. and Stomatohabitantales ord. nov”为题发表在Systematic and Applied Microbiolog学术期刊上,2023白菜网址官网大全为该成果的第一完成单位。
原文链接: